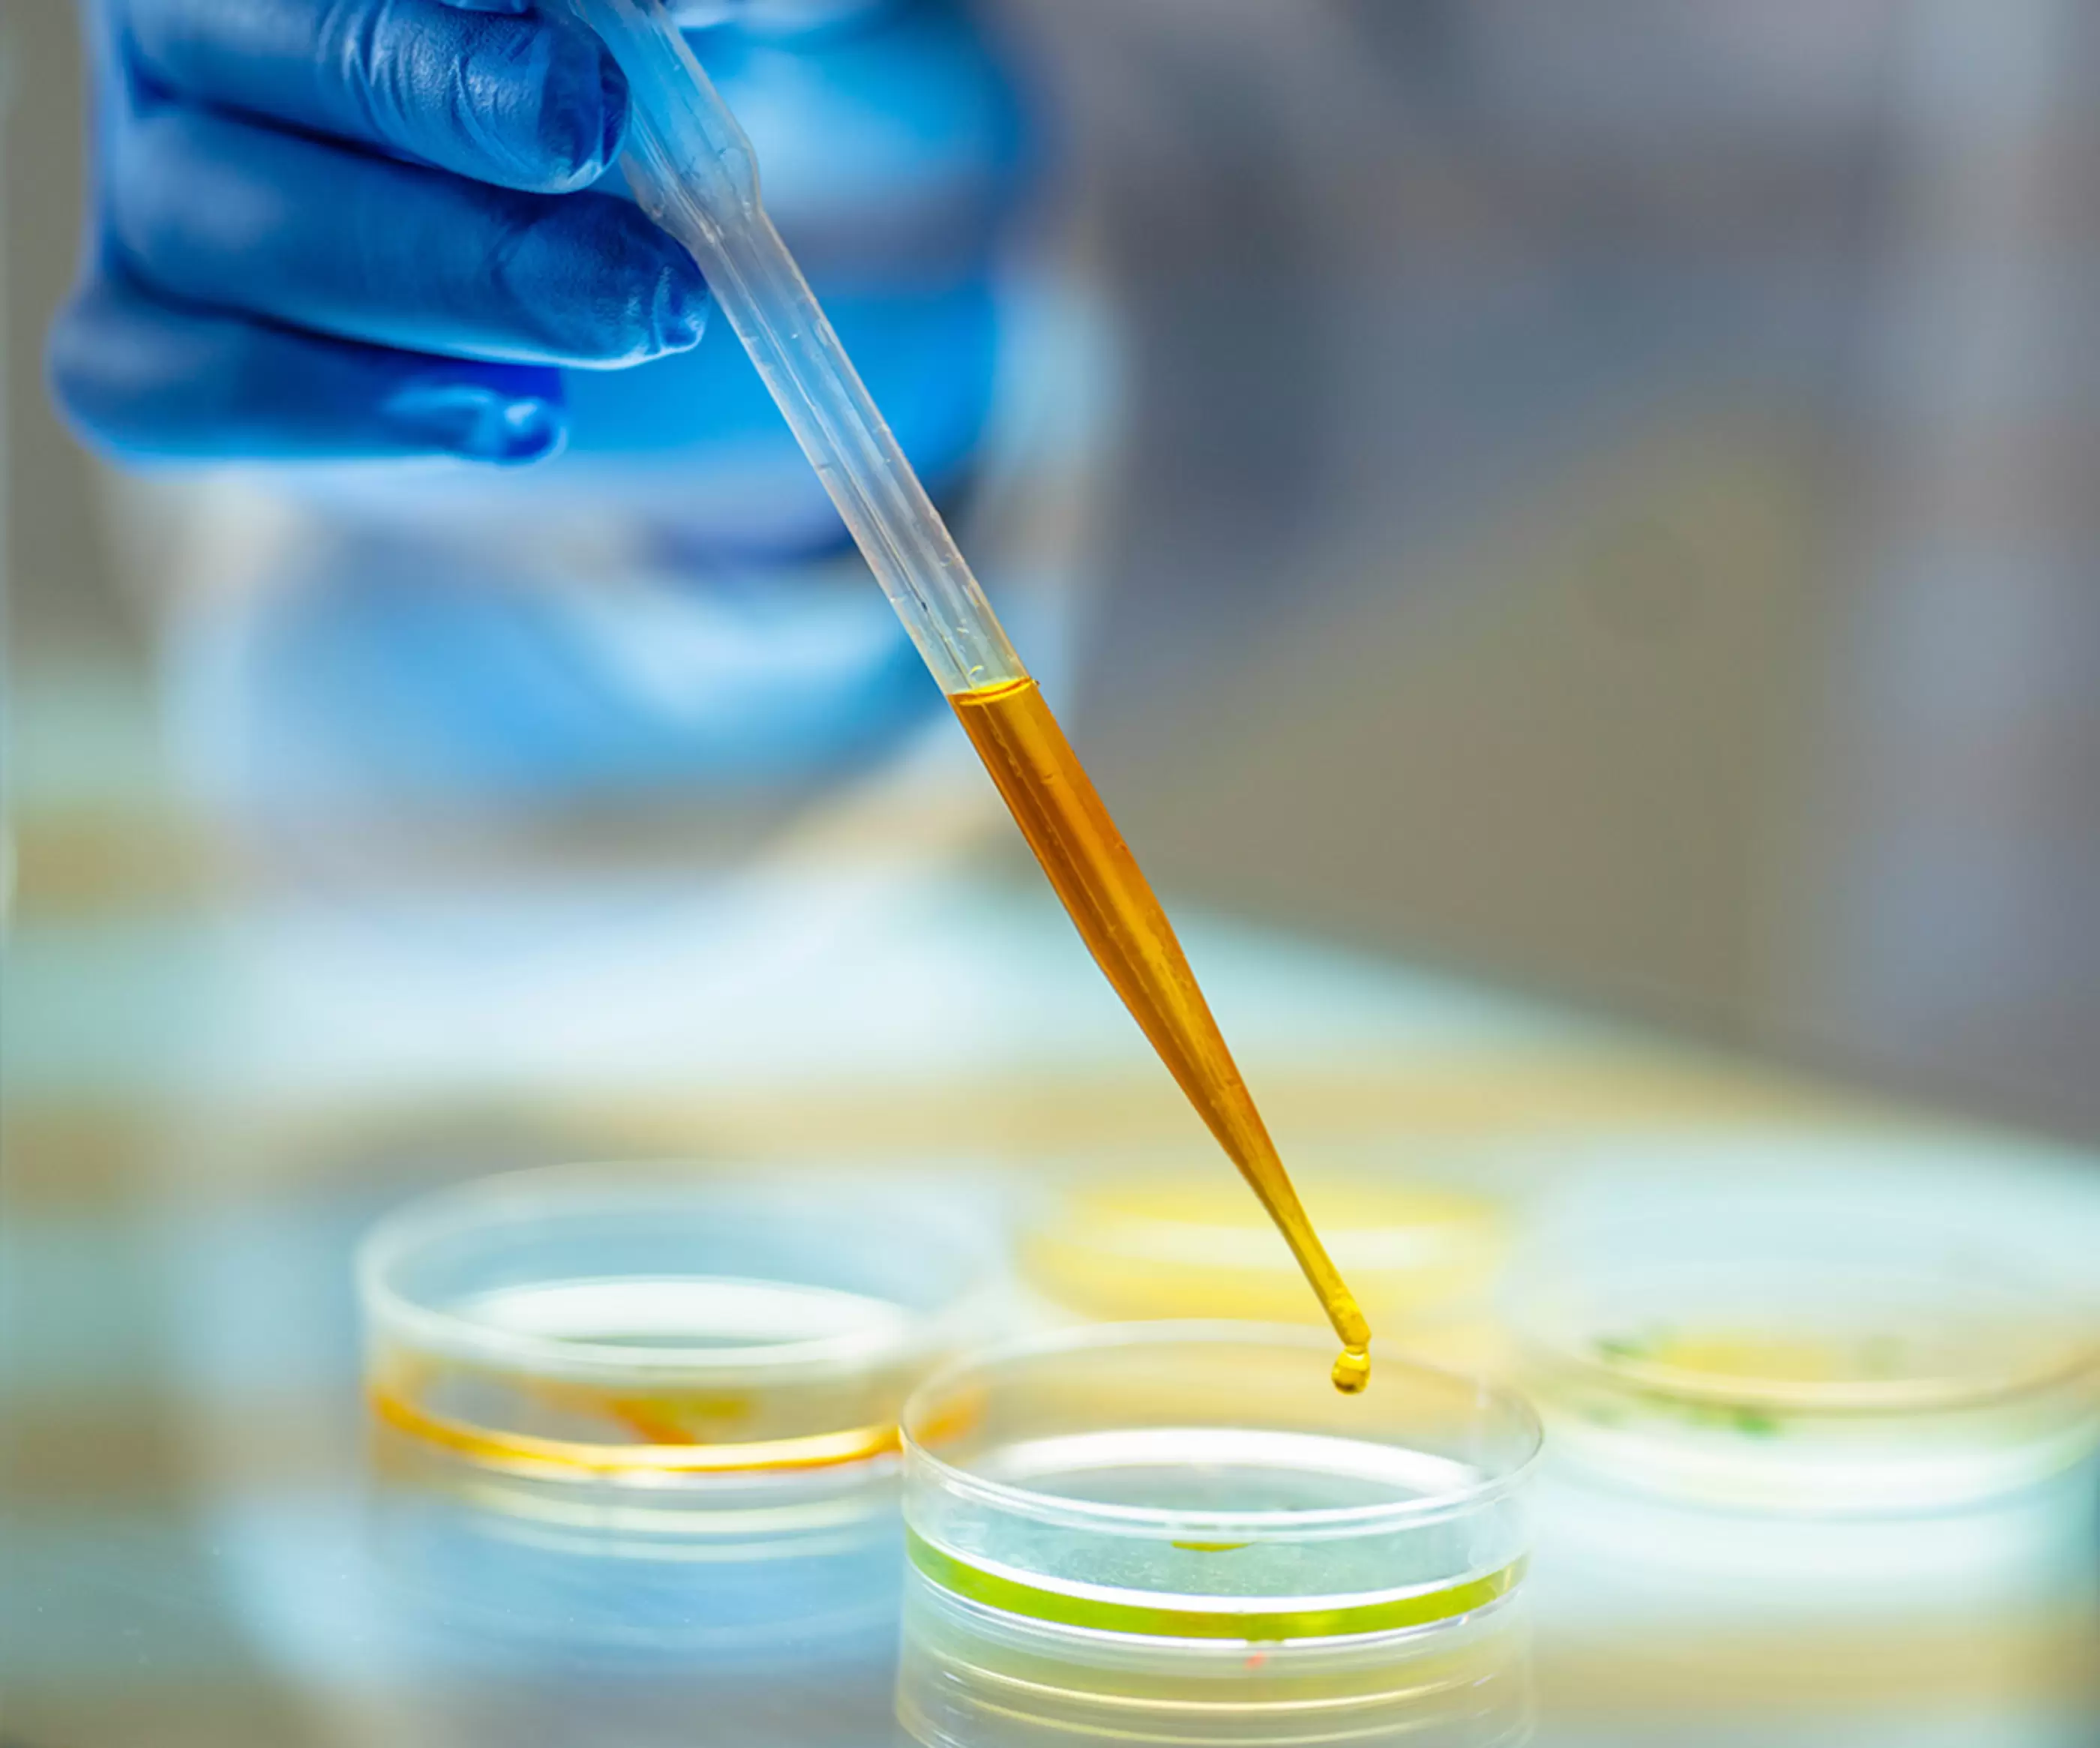

We handle more than 10,000 products and serve more than 2,000 customers in plastic materials and additives, industrial oil materials, plating chemicals, water processing agents, photoresist materials, fluorochemicals, silicone, 3D, and more. We also manufacture Denafilter™, a filtration system used in the manufacturing process of high quality films for packaging and optical applications.

Chemicals
Navigating international trade, a complex supply chain, and ever-evolving regulations takes a partner with a customer-first approach. With global access to unique raw materials, and a variety of intermediates for use in specialty and performance chemical applications, we can help you with all your chemical ingredient needs.
A Comprehensive Chemicals Portfolio
We offer a wide range of chemical products from the most technologically advanced manufacturers for a variety of industrial applications, such as textile, films, coatings, adhesives, and more. Our open collaboration and experienced partner network enable us to deliver superior formulations and chemical technologies to meet even your most challenging project requirements.
Focus Areas
Specialty Chemicals
Performance Chemicals
From general-purpose petrochemical products to high value-added materials, we leverage our manufacturing and R&D functions to provide a broad range of chemical services to the global market. This includes our Carbon Hybrid Coating System which uses carbon dioxide gas to reduce volatile organic compounds (VOC) in paints. Our raw materials businesses for the paint, ink, and urethane industries are each recognized as established leaders in their respective markets.
Color and Processing
We specialize in paint, ink, paper, and film converter chemicals with a focus on organic and inorganic compounds, such as dyes and pigments. We leverage proprietary data to improve the visual appeal of our premium colors, materials, and functions for the paints, coating materials, adhesives, and chemicals for paper manufacturing that we offer.

Setting Higher Standards in the Chemicals Industry
We’re dedicated to supplying quality products and maintaining a highly integrated system of checks and balances in line with ISO 14001 Certification to ensure each batch is consistent. We’ve acquired all necessary quality certificates required in the encapsulants, conductive inks, and adhesive industries.
We combine our core technologies in synthesis, formulation, and biotechnology to maximize our capabilities and develop completely novel materials, accelerate R&D, and increase the speed at which we can solve important technical issues.
We are dedicated to the safe handling of chemicals. Our management system ensures we properly comply with any laws or regulations that affect our products. We also participate in the Japan Chemical Industry Association's Responsible Care Committee to promote safe chemical handling. Our own responsible care activities aim to preserve the environment and ensure health and safety from development to disposal.
See Chemical Products
Explore our products and solutions for the chemicals industry.
Featured Resources
We’re Here to Help
Complete the following fields with your information, as well as a short, detailed description of your request and a NAGASE Specialist will be in touch with you shortly.